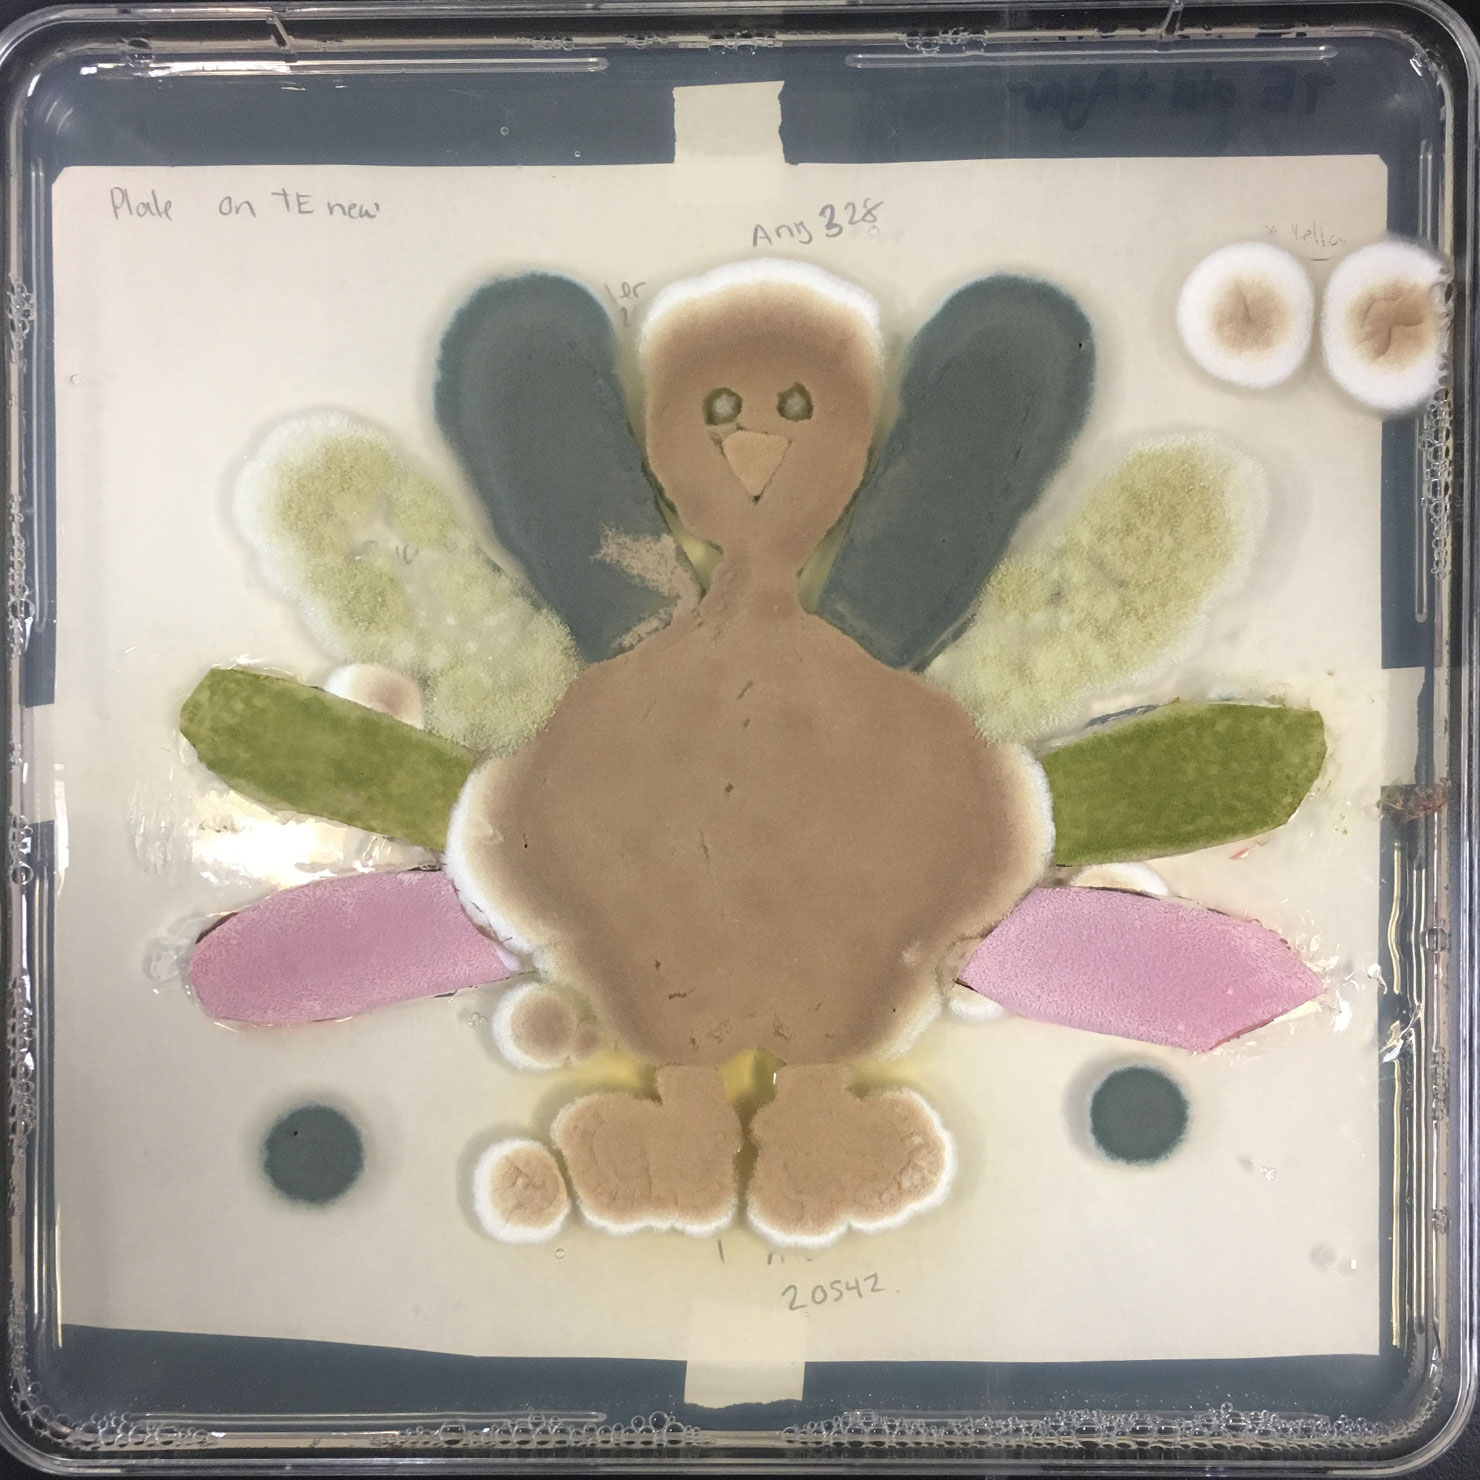

How to Bake a (Fungal) Turkey

From the kitchen of Stephanie Mounaud, Scientific Project Manager at JCVI
Ingredients
- Media base (see media recipe)
- Agar
- Aspergillus terreus (multiple strains)
- Aspergillus niger
- Aspergillus fumigatus
- Aspergillus oryzae
- Pencillium marneffi
- Aspergillus flavus
Instructions
Start with a complex mixture of chemicals to make trace elements media. Sprinkle a little agar in there to get things solidified. Attach reference turkey art to the back of your plates. Pour media onto plates to about half full. Add in a little Aspergillus terreus to make the feet and beak. Throw in another variant of Aspergillus terreus to fatten up the body. This will create great flavor with a slightly different pigment. Sprinkle in a VERY small amount of Aspergillus niger to make noticeably dreamy, dark eyes. Don’t overdo this one, it will completely take over if too much is added. For rich feathers use Aspergillus fumigatus and Aspergillus oryzae. Make sure these are fresh. If these are old they will result in diluted, spotty flavor. Let your turkey grow and mature at room temperature for several days. If your turkey needs a little boost you can warm it up to 37°C for a day or two.

Useful Tip: To get vibrant feather colors you can use Pencillium marneffi and Aspergillus flavus, but let these simmer in some Sabouraud Dextrose Agar for a few days at room temperature. You can then add these to your main dish.
If you think this is cool, see how our scientists are working to take a bite out of oral cancer through innovative microbiome research.